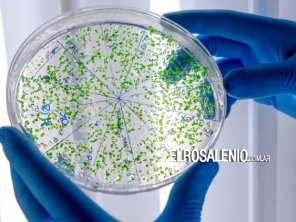
¿Cuánto plástico consumimos por semana sin darnos cuenta?

HISTORIAL DE NOTICIAS | INTERÉS GENERAL
INTERÉS GENERAL | 20/05/2024
El Comando de Adiestramiento y Alistamiento de la Armada (COAA), mantiene abierta hasta el 5 de junio la inscripción al Concurso Abierto de Antecedentes y Oposición, para cubrir cargos docentes en las materias y niveles que a continuación se...
INTERÉS GENERAL | 18/05/2024
Cumpliendo con lo acordado, y en un contexto de dificultad financiera provocada por las políticas del Gobierno Nacional, la Provincia retomó hoy las negociaciones paritarias con los gremios docentes a quienes ofreció un nuevo tramo de aumento...
INTERÉS GENERAL | 17/05/2024
A partir de la tarde de este viernes, entrará en vigencia el nuevo valor en la tarifa del Estacionamiento Medido y Pago, luego del incremento de 23,6% en todas las tasas municipales aplicado en forma automática en base al informe de inflación del...
INTERÉS GENERAL | 17/05/2024
El subsecretario de Recursos Hídricos del Ministerio de Infraestructura y Servicios Públicos de la provincia de Buenos Aires, Néstor Álvarez, y el intendente de Bahía Blanca, Federico Susbielles, recorrieron la obra de recambio del acueducto...
INTERÉS GENERAL | 17/05/2024
El elemento más común con el que vivimos diariamente, que utilizamos, o que vemos a nuestro alrededor todo el tiempo es uno solo: el plástico.
Desde los envases de comida o bebida que consumimos, hasta las cosas que usamos a diario están...
Desde los envases de comida o bebida que consumimos, hasta las cosas que usamos a diario están...
INTERÉS GENERAL | 17/05/2024
Esta semana el Municipio dio inicio a la colocación de 20 luminarias LED en la calle Mitre, como parte de un plan de instalación de 44 nuevos artefactos. “Es el comienzo de una transformación lumínica”, dijeron desde el Municipio en un...
INTERÉS GENERAL | 16/05/2024
La Plaza de Armas de la Escuela de Suboficiales de la Armada (ESSA) dio la bienvenida a una nueva generación de marinos: los Aspirantes Navales de la Promoción 125 que finalizaron su formación y próximamente se presentarán en sus respectivos...
INTERÉS GENERAL | 16/05/2024
Vecinos de calle Estomba al 800, enviaron imágenes de la enorme acumulación de agua que se registra en esa calle, a raíz de una importante pérdida de agua por un caño roto.
“Es terrible la pérdida de agua, ya avisamos a ABSA pero no...
“Es terrible la pérdida de agua, ya avisamos a ABSA pero no...
INTERÉS GENERAL | 16/05/2024
En el marco del Día de la Armada y el Día Internacional de los Museos, el Complejo Histórico Patrimonial de la Base de Infantería de Marina Baterías abrirá sus puertas este sábado de 14 a 18hs.
Con entrada libre y gratuita, los asistentes...
Con entrada libre y gratuita, los asistentes...
INTERÉS GENERAL | 16/05/2024
Desde el Concejo Deliberante local se expresó preocupación, ante las demoras en el giro de los fondos de parte del Estado nacional a las empresas distribuidoras de gas, además del intento trunco del gobierno para eliminar los subsidios por zona...